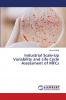
Industrial Scale-Up Variability and Life Cycle Assessment of MFCs

English
Paperback
₹3985
(All inclusive*)
Delivery Options
Please enter pincode to check delivery time.
*COD & Shipping Charges may apply on certain items.
Review final details at checkout.
Looking to place a bulk order? SUBMIT DETAILS
About The Book
Description
Author
Industrial Scale-Up Variability And Life Cycle Assessment Of Mfcs by Harshit Mittal published by Lap Lambert Academic Publishing stands as a beacon of knowledge and inspiration. With its insightful content and engaging narrative style this book transcends genres offering something valuable for every reader.
Delivery Options
Please enter pincode to check delivery time.
*COD & Shipping Charges may apply on certain items.
Review final details at checkout.
Details
ISBN 13
9786208422219
Publication Date
-15-01-2025
Pages
-60
Weight
-95 grams
Dimensions
-150x220x3.68 mm